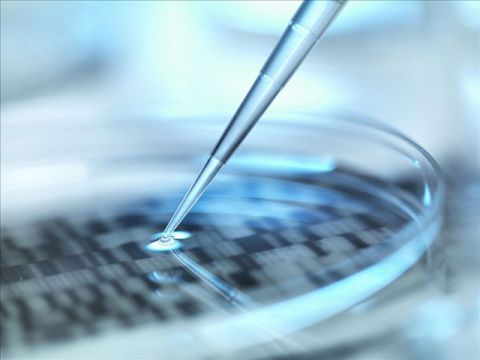

定點突變
技術簡介
定點突變是通過PCR等方法向目的DNA片段(可以是基因組,也可以是質粒)中引入所需變化(包括堿基的添加,缺失,以及堿基的替換)來改造基因。定點突變能迅速、高效地改變DNA所表達的目的蛋白的性狀及表征,是研究蛋白質結構和功能之間復雜關系的有力工具,也是研究人員在實驗室中改造、優化基因常用的一種非常有用的手段。
體外定點突變技術是當今分子生物學功能實驗和醫學研究領域的核心技術。該技術通過修改克隆上的堿基從而改變功能序列的編碼特性,廣泛應用于各種領域研究:基因調控因子,DNA和蛋白互作,蛋白結構和功能,酶學活性位點的確定等,定點突變還是深入研究基因功能必須進行的實驗。

應用領域
1. 基因和蛋白質功能研究。
2. DNA疫苗和抗體的研究。
3. 藥物的研發篩選。
4. 遺傳病的研究和治療。
5. 蛋白互作研究、酶學活性位點的確定。
服務內容
| 服務項目 | 分類 |
| 基因定點突變 | 目的基因或質粒單點、多點突變或隨機突變 |
| 含有重復序列或高GC序列定點突變服務 | |
| 基因合成突變 |
注:
1. 相鄰的兩個堿基突變(40bp以內)按照一個點收費;更大的基因,更多的點突變請詢價;
2. 1kb以下的DNA片段克隆在普通載體上的單點突變的時間約需10天左右。如遇到特殊情況,我們會及時和客戶聯系,保證盡早發貨。
技術優勢
1.定點突變的基因片段經測序驗證,保證100%的準確性。
2.各種點突變形式,也可以進行大片段的刪除/插入等突變。
3.轉導生物專業團隊擁有豐富經驗、精湛技術,確保實驗高效完成。
技術流程(圖)
引物設計——PCR條件摸索——測序篩選突變體

您需要提供以下材料:
1. 實驗材料:突變的質粒、載體或DNA片段;
2. 序列信息:突變基因的全部詳細序列 突變后序列;
3. 方案與要求:實驗的具體要求以及突變基因克隆的詳細背景資料,如克隆于何種載體,使用何種限制酶切位點。
您將獲得以下實驗結果:
1. 實驗操作過程,突變用引物序列;
2. 凍干后的測序質粒及含有改質粒的甘油保存菌;
3. 相應的改造前后的DNA測序結果。
定點突變質粒測序結果:
